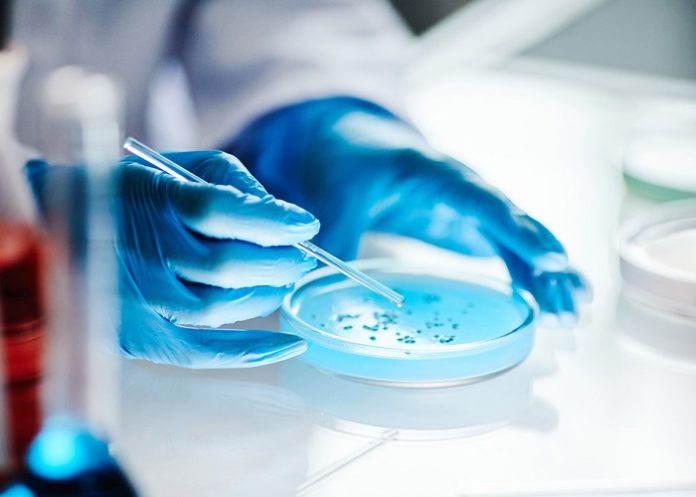

Wits University scientists have identified a “microbial watchlist” of bacteria, viruses, fungi and parasites that could cause cancer, saying that understanding these microbial links could unlock a new wave of prevention strategies.
Thus, targeting common infections in Africa, such as Salmonella typhi and the Epstein-Barr virus, may be among the most effective cancer-prevention strategies for the continent, they suggest.
Infections shape the immune system, alter tissue environments, and induce chronic inflammation, increasing the risk of carcinogenesis.
A recent review by the scientists at the Wits Antiviral Gene Therapy Research Unit (AGTRU) and the Wits Infectious Diseases and Oncology Research Institute (Wits-IDORI) projects that cancer incidence in sub-Saharan Africa will double by 2040.
Many people are diagnosed late and have limited access to specialised treatment, and new cancer drugs are often unaffordable.
“We believe that there are many more microbial links to cancer that have not been characterised in African populations,” said AGTRU’s Dr Rebecca van Dorsten. “If scientists can identify the microbes that influence cancer risk, they can intervene early and at low cost.”
Van Dorsten and Distinguished Professor Robert Breiman, senior scientific adviser for IDORI, propose a modern framework to determine whether a microbe plays a causal role in cancer. It builds on traditional tools, such as Koch’s postulates and the Bradford Hill criteria, which are effective for acute infections and environmental exposures but are less applicable to diseases that manifest years after the initial environmental exposure.
The framework introduced in the review incorporates historical population data, as well as molecular, genomic, and experimental data, to capture the gradual, multi-step nature of cancer formation.
Using this approach, the review examines several microbes common in African settings that may contribute to cancer risk. For example, Salmonella Typhi, the cause of typhoid fever, can persist in the gallbladder for years in a small proportion of people. International studies suggest that this chronic state may increase the risk of gallbladder cancer.
Very little research on gallbladder cancer has been conducted in Africa, however, despite the continent’s high typhoid burden.
Meanwhile, Schistosoma haematobium, the parasite responsible for urinary schistosomiasis, is widespread in parts of southern Africa. It is already a confirmed cause of bladder cancer. Schistosoma species found in East and Southeast Asia are also linked to cancers of the liver and bile ducts.
By early adulthood, most people in Sub-Saharan Africa carry cytomegalovirus (CMV). Some studies have detected CMV genetic material in glioblastoma and breast cancer tissues. Although the evidence is inconsistent, the possibility of CMV contributing to cancer progression is being taken seriously because of its high prevalence and its ability to alter immune and metabolic pathways.
Epstein-Barr virus has long been associated with Burkitt lymphoma, a cancer that predominantly affects children in malaria-endemic regions of Africa. Epstein-Barr may also contribute to stomach, head and neck cancers. Its effects may be amplified in immunosuppressed individuals, including those living with HIV.
Other microbes, such as Fusobacterium nucleatum, a bacterium commonly found in the mouth and gut, are increasingly associated with colorectal cancer. Studies in several countries have shown that F. nucleatum can infiltrate tumour tissue and may enhance tumour growth and spread.
The African data on this topic are minimal, even though colorectal cancer rates are rising in many urban centres.
Fungal toxins remain a major concern. Aspergillus species thrive in hot, humid environments and contaminate staple crops when storage conditions are inadequate. These fungi produce aflatoxin, one of the most potent naturally occurring carcinogens, and a major driver of liver cancer in regions of West and East Africa where maize and groundnuts form a large portion of the diet.
Van Dorsten says that understanding these microbial links could unlock a new wave of prevention strategies.
“Vaccines, improved food storage, antimicrobial treatment and parasite control are all practical and affordable when compared with advanced cancer therapies.”
She notes that African cancer research must start with African data. Local exposures, co-infections, and immune environments shape how cancers develop, and these patterns cannot be inferred from studies conducted elsewhere.
The authors say that by identifying the microbes that influence cancer risk in Africa, scientists and health authorities can develop interventions long before tumours develop. This could save thousands of lives and reduce the growing cancer burden in a region where treatment options remain limited.
Breiman adds that Wits-IDORI is prioritising the discovery of novel links between infectious diseases and cancer. “We know that nearly all cervical cancers are caused by human papillomavirus, and this ultimately led to the development and use of viral vaccines to prevent cancers. This was far-fetched when I was in medical school, but now we believe that cervical cancer can be eliminated as a significant public health problem.
“Exploring the nexus of microbes and cancer will illuminate practical pathways for reducing the massive burden of mortality due to cancer in Africa and globally.”
See more from MedicalBrief archives:
Cancer deaths to top 18m in 2050 – The Lancet
Pioneering project to build first cancer database in Africa
Global study to determine why black people have worse cancers
Unequal burden of prostate cancer for Africa
Experts call for comprehensive, large-scale response to slash Africa’s cancer burden